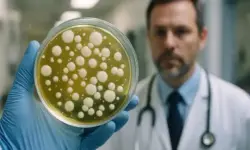

Noch ist sie nicht beschlossene Sache, doch die Debatte um eine Rente mit 70 gewinnt in Deutschland zunehmend an Brisanz. Während Politiker, Ökonomen und Gewerkschaften diskutieren, was eine längere Lebensarbeitszeit bedeutet, wächst in der Bevölkerung das Unbehagen. Wer muss künftig wirklich bis 70 arbeiten – und für wen bleibt das eine politische Phantomdebatte?
Einordnung: Woher kommt die Idee der Rente mit 70?
Die Forderung nach einer Anhebung des Renteneintrittsalters auf 70 Jahre ist nicht neu. Schon seit Jahren weisen Wirtschaftsforschungsinstitute und internationale Organisationen darauf hin, dass die steigende Lebenserwartung und der demografische Wandel die Rentensysteme unter Druck setzen. In Deutschland wird das gesetzliche Renteneintrittsalter aktuell schrittweise auf 67 Jahre angehoben – für alle ab dem Geburtsjahrgang 1964. Doch mit dem Ende dieser Übergangsphase stellt sich nun eine neue Frage: Ab wann könnte das Renteneintrittsalter auf 70 steigen?
Modellrechnungen zeigen, dass eine Anhebung auf 70 Jahre nicht vor 2070 oder gar 2090 realistisch ist – vorausgesetzt, die Lebenserwartung steigt weiterhin gleichmäßig. Derzeit beträgt die durchschnittliche Lebenserwartung in Deutschland rund 81 Jahre. Mit einer jährlichen Steigerung von etwa 0,1 Jahren könnte eine Rente mit 70 erst dann sachlich begründbar sein, wenn die Lebenserwartung nahe an 86 Jahre heranreicht.
Positionen aus der Politik: Uneinigkeit in allen Lagern
In der politischen Debatte sind die Fronten keineswegs klar gezogen. Während der wirtschaftsnahe Flügel der CDU offen über eine Rente mit 70 nachdenkt, erteilte Parteichef Friedrich Merz dieser Idee eine deutliche Absage: „Das geht einfach nicht.“ Auch SPD-Kanzler Olaf Scholz und Arbeitsminister Hubertus Heil lehnen die Anhebung strikt ab. Heil bezeichnete die Diskussion als „Phantomdebatte“. Dennoch kam jüngst Bewegung in die Sache: Bundestagspräsidentin Bärbel Bas (SPD) erklärte, sie könne sich eine Rente mit 70 unter bestimmten Bedingungen vorstellen – etwa wenn auch Beamte und Selbstständige in die gesetzliche Rentenversicherung einzahlen würden.
Rente mit 70: Was sagen Gewerkschaften und Verbände?
Was sagen Gewerkschaften zur Rente mit 70 Forderung? Die Reaktion der Gewerkschaften ist eindeutig. Sowohl die IG Metall als auch der Deutsche Gewerkschaftsbund (DGB) kritisieren die Idee als verkappte Rentenkürzung. Die Argumentation: Wer länger arbeiten muss, bekommt später Rente – oft bei gesundheitlich eingeschränkter Leistungsfähigkeit und kürzerer Lebensdauer. Gerade Menschen mit geringen Einkommen oder in körperlich fordernden Berufen seien besonders betroffen.
Ein Sprecher der IG Metall stellte klar: „Die Rente mit 70 ist keine Lösung, sondern ein sozialer Rückschritt.“ Besonders deutlich zeigt sich die Ablehnung in den handwerklichen Gewerken. Dachdecker, Pflegekräfte oder Bauarbeiter schaffen es häufig schon jetzt nicht, bis zur regulären Grenze von 67 Jahren im Beruf zu bleiben.
Wer könnte realistischerweise nicht bis 70 arbeiten?
Eine Untersuchung des Wirtschafts- und Sozialwissenschaftlichen Instituts (WSI) ergab, dass rund 25 % der Beschäftigten in Deutschland nicht davon ausgehen, bis zur gesetzlichen Grenze arbeiten zu können. Der Grund: körperliche und psychische Belastungen. Besonders betroffen sind körperlich tätige Berufe wie Maurer, Lkw-Fahrer oder Krankenpfleger.
Die Idee, künftig einzelne Berufsgruppen zu unterscheiden, wird deshalb vermehrt diskutiert. Der baden-württembergische Finanzminister Danyal Bayaz (Grüne) brachte die Idee ins Spiel, dass Akademiker – abhängig von Bildungsgrad – später in Rente gehen könnten als körperlich stark belastete Berufsgruppen.
Internationale Perspektive: Wie macht es Europa?
Gibt es in Europa schon Rente mit 70 Land? Ein Blick nach Europa zeigt, dass Deutschland mit seiner aktuellen Regelung im internationalen Vergleich moderat aufgestellt ist. In Dänemark wurde bereits beschlossen, das Renteneintrittsalter schrittweise bis auf 70 Jahre zu erhöhen – für alle ab dem Geburtsjahrgang 1971. Auch in den Niederlanden gibt es Überlegungen, das Rentenalter automatisch mit der Lebenserwartung zu koppeln. In vielen anderen Ländern der EU wird ebenfalls mit dynamischen Rentensystemen experimentiert.
Wirtschaft und Wissenschaft: Was empfehlen Experten?
Der Sachverständigenrat und führende Ökonomen empfehlen eine Flexibilisierung des Renteneintrittsalters. Statt einer starren Grenze solle ein Renteneintrittsfenster geschaffen werden – etwa zwischen 63 und 70 Jahren. Wer früher in Rente geht, erhält weniger. Wer länger arbeitet, wird belohnt.
Ein konkretes Beispiel: Wie viel mehr Rente bringt Arbeiten bis 70 Prozent? Wer bis 70 Jahre arbeitet, statt mit 67 in Rente zu gehen, kann mit rund 12 bis 18 % mehr monatlicher Rente rechnen – je nach Beitragsdauer und Entgeltpunkten. Dieser Anreiz soll freiwilliges Weiterarbeiten attraktiver machen.
Erwerbstätigkeit im Alter: Deutschland im Hintertreffen
Im Vergleich zu anderen OECD-Ländern liegt Deutschland bei der Erwerbstätigkeit älterer Menschen zurück. Nur rund 9 % der 65- bis 69-Jährigen arbeiten noch – in Ländern wie Schweden oder Japan sind es deutlich über 15 %. Die Bundesregierung setzt daher zunehmend auf „aktive Altersteilnahme“: Menschen sollen freiwillig länger im Erwerbsleben bleiben können, etwa durch flexible Arbeitszeitmodelle oder steuerliche Vorteile.
Gesellschaftlicher Blick: Privilegien und Gerechtigkeit
In sozialen Medien und Foren, etwa auf Reddit oder Twitter (X), ist eine klare Meinung zu erkennen: Viele Menschen empfinden die Debatte als ungerecht. Ein wiederkehrendes Argument: „Solange Politiker ihre eigenen Pensionsregelungen haben, ist eine Rente mit 70 für Normalbürger unzumutbar.“ Auch die strukturelle Ungleichbehandlung zwischen körperlich und geistig fordernden Berufen wird vielfach kritisiert. Das Vertrauen in die Gerechtigkeit des Systems sinkt.
Altersarmut als unterschätzte Gefahr
Parallel zur Debatte um das Rentenalter nimmt die Angst vor Altersarmut zu. Die Kombination aus niedrigem Rentenniveau, steigenden Lebenshaltungskosten und unsicheren Arbeitsverhältnissen führt dazu, dass viele Bürger mit Sorge in die Zukunft blicken. Ein Reddit-Nutzer brachte es auf den Punkt: „Was bringt mir eine Rente mit 70, wenn ich keine Wohnung mehr bezahlen kann?“
Technologische Lösung? Alternsgerechtes Arbeiten
Eine alternative Herangehensweise diskutieren Arbeitswissenschaftler: Statt das Rentenalter zu erhöhen, sollten die Arbeitsplätze altersgerecht gestaltet werden. Das umfasst ergonomisch optimierte Arbeitsumgebungen, Weiterbildungsangebote für ältere Mitarbeitende, sowie zeitlich flexible Arbeitszeitmodelle. In der Industrie werden sogar erste Exoskelette getestet, die körperlich schwere Tätigkeiten erleichtern sollen.
Welche Reformen sind denkbar?
Immer häufiger wird ein sektoral differenziertes Modell diskutiert: Je nach Bildungsgrad, körperlicher Belastung und Tätigkeitsprofil könnte das Rentenalter individuell angepasst werden. Gleichzeitig sollen Anreize für freiwillige längere Erwerbstätigkeit verbessert werden – nicht durch Zwang, sondern durch Belohnung.
Ein weiterer Vorschlag lautet, das Rentensystem insgesamt breiter aufzustellen: Einbezug von Selbstständigen und Beamten, Einführung einer Erwerbstätigenversicherung, stärkere Förderung betrieblicher und privater Vorsorge.
Schlussbetrachtung: Zwischen Realität, Verantwortung und Vertrauen
Die Frage „Wer ist gegen Rente mit 70?“ lässt sich nicht pauschal beantworten – denn selbst innerhalb der Parteien und Verbände herrscht Uneinigkeit. Fest steht aber: Eine pauschale Erhöhung des Renteneintrittsalters auf 70 Jahre wird in der breiten Bevölkerung auf Widerstand stoßen, solange nicht gleichzeitig für Ausgleich, Fairness und soziale Sicherheit gesorgt wird.
Die Herausforderung besteht darin, ein Rentensystem zu schaffen, das die demografische Realität anerkennt und zugleich gerecht bleibt. Eine starre Grenze bei 70 Jahren würde vielen nicht gerecht – ein flexibler, auf Lebensrealitäten abgestimmter Übergang hingegen könnte den Spagat zwischen wirtschaftlicher Notwendigkeit und sozialer Verantwortung meistern. Solange dieser Ausgleich nicht gelingt, bleibt die Rente mit 70 vor allem eines: eine Debatte – mit offenem Ausgang.